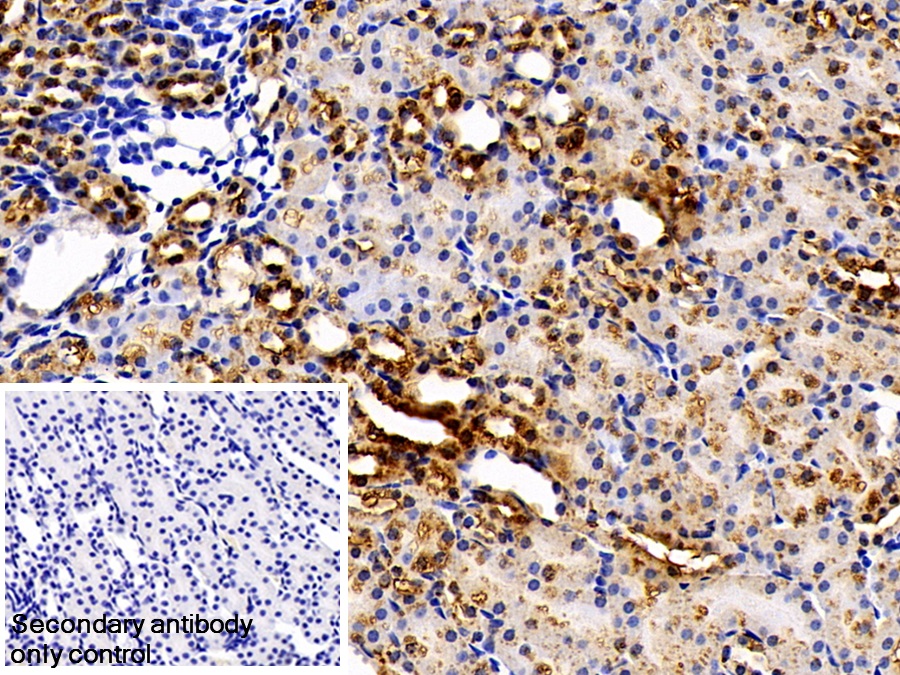

过氧化还原酶5(PRDX5)多克隆抗体
Polyclonal Antibody to Peroxiredoxin 5 (PRDX5)
PLP; PRDX6; ACR1; PMP20; PRXV; SBBI10; Thioredoxin Peroxidase PMP20; Peroxisomal Antioxidant Enzyme; TPx Type VI; Liver Tissue 2D-Page Spot 71B; Alu Co-Repressor 1
- 编号PAF755Hu01
- 物种Homo sapiens (Human,人)相同的名称,不同的物种。
- 来源多抗制备
- 宿主兔
- 效价-
- Ig类型IgG
- 纯化方式抗原特异性亲和纯化
- 标记物无标记物
- 免疫原RPF755Hu01-过氧化还原酶5(PRDX5)重组蛋白
- 缓冲液成份磷酸盐缓冲液(pH7.4,含有0.02% NaN3和50%甘油)
- 性状液体
- 浓度500µg/mL
- 且适物种Mus musculus (Mouse,小鼠)
- 应用WB; IHC; ICC/IF; FCM
如果抗体需用于流式细胞术,请参见流式抗体。 - 下载英文说明书 中文说明书
- 规格20µl100µl200µl1ml10ml
- 价格¥ 630¥ 1470¥ 2100¥ 5250¥ 21000
- 欲了解实际交易价格和更多情况,请与当地经销商联系!
特异性
该抗体是针对PRDX5的兔多克隆抗体。在免疫组织化学染色和免疫印迹实验中能识别PRDX5。
用法
Western blotting: 0.2-2μg/mL;
Immunohistochemistry: 5-20μg/mL;
Immunocytochemistry: 5-20μg/mL;
Flow cytometry:20μg/ml;
Optimal working dilutions must be determined by end user.
储存
经常使用则4°C保存。-20°C保存不超过两年。避免反复冻融。
稳定性
热稳定性以损失率显示。损失率是由加速降解试验决定,具体方法如下:在37°C孵育48小时,没有显著的降解或者沉淀产生。保质期内,在适当的条件下存储,损失率低于5%。
赠品
增值服务
相关产品
| 编号 | 适用物种:Homo sapiens (Human,人) | 应用(仅供研究使用,不用于临床诊断!) |
| RPF755Hu01 | 过氧化还原酶5(PRDX5)重组蛋白 | Positive Control; Immunogen; SDS-PAGE; WB. |
| PAF755Hu01 | 过氧化还原酶5(PRDX5)多克隆抗体 | WB; IHC; ICC/IF; FCM |
| LAF755Hu81 | 过氧化还原酶5(PRDX5)多克隆抗体(异硫氰酸荧光素标记) | WB; IHC; ICC; IF. |
| LAF755Hu71 | 过氧化还原酶5(PRDX5)多克隆抗体(生物素标记) | WB |
| MAF755Hu21 | 过氧化还原酶5(PRDX5)单克隆抗体 | WB; IHC; ICC; IP. |
| SEF755Hu | 过氧化还原酶5(PRDX5)检测试剂盒(酶联免疫吸附试验法) | Enzyme-linked immunosorbent assay for Antigen Detection. |
| LMF755Hu | 过氧化还原酶5(PRDX5)等多因子检测试剂盒(流式荧光发光法) | FLIA Kit for Antigen Detection. |
参考文献
| 杂志 | 参考文献 |
| Stroke | Peroxiredoxin 5 (PRX5) Is Correlated Inversely to Systemic Markers of Inflammation in Acute Stroke[Pubmed: 24385276] |